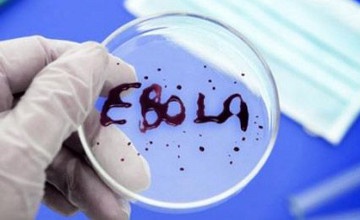
Алматыда «Эбола» безгегіне күдікпен ұсталған адамның сараптама қорытындысы 18-20 сағаттың ішінде анықталады

Алматыда «Эбола» безгегіне күдікпен ұсталған адамның сараптама қорытындысы 18-20 сағаттың ішінде анықталады
«Эбола» безгегіне шалдығуы мүмкін деген күдікпен Алматы әуежайында ұсталған адамға қатысты сараптама қорытындысы 18-20 сағаттан кейін белгілі болады, деп хабарлады ҚР Ұлттың экономика министрлігінің баспасөз қызметі.
15 наурызда Алматы халықаралық әуежайында ҚР Ұлттық экономика министрлігінің Тұтынушылардың құқығын қорғау комитеті санитарлық-карантиндік пунктінің мамандары сағат 6.55-те Гвинея-Стамбұл-Алматы бағытындағы №350 рейс жолаушыларының арасында болған «Эбола» безгегіне күдікті ер адамды күтіп алды.
«Эпидемиялық тексеру барысында мамандар аурудың наурыздан 9-нан 14-не дейінгі аралықта Гвинеяда іссапармен болғандығын анықтады. Ал, ол отырған ұшақ санитарлық тұраққа жөнелтіліп, бортта болған 126 жолаушының барлығы қатаң бақылауға алынды. Сондай-ақ, ол 126 адаммен қарым-қатынас жасаған.
Қазір науқастың дене қызуы қалыпты. Әзірге оған өткір респираторлық вирус жұқтырды деген диагноз қойылып отыр», делінген хабарламада.
Сондай-ақ оқыңыз
Барлығы






